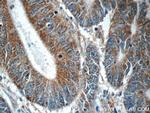
PHLPPL Antibody in Immunohistochemistry (Paraffin) (IHC (P))
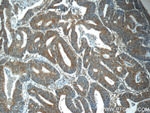
PHLPPL Antibody in Immunohistochemistry (Paraffin) (IHC (P))

Search
Proteintech
PHLPPL Polyclonal Antibody
{{$productOrderCtrl.translations['antibody.pdp.commerceCard.promotion.promotions']}}
{{$productOrderCtrl.translations['antibody.pdp.commerceCard.promotion.viewpromo']}}
{{$productOrderCtrl.translations['antibody.pdp.commerceCard.promotion.promocode']}}: {{promo.promoCode}} {{promo.promoTitle}} {{promo.promoDescription}}. {{$productOrderCtrl.translations['antibody.pdp.commerceCard.promotion.learnmore']}}
产品信息
25244-1-AP
种属反应
已发表种属
宿主/亚型
分类
类型
抗原
偶联物
形式
浓度
规格
纯化类型
保存液
内含物
保存条件
运输条件
产品详细信息
Immunogen sequence: LDLQHNALT RLPDTLFSKA LNLRYLNASA NSLESLPSAC TGEESLSMLQ LLYLTNNLLT DQCIPVLVGH LHLRILHLAN NQLQTFPASK LNKLEQLEEL NLSGNKLKTI PTTIANCKRL HTLVAHSNNI SIFPEILQLP QIQFVDLSCN DLTEILIPEA LPATLQDLDL TGNTNLVLEH KTLDIFSHIT TLKIDQKPLP TTDSTVTS (575-781 aa encoded by BC129927)
靶标信息
Protein phosphatase involved in regulation of Akt and PKC signaling. Mediates dephosphorylation in the C-terminal domain hydrophobic motif of members of the AGC Ser/Thr protein kinase family; specifically acts on 'Ser-473' of AKT1, 'Ser-660' of PRKCB isoform beta-II and 'Ser-657' of PRKCA. Akt regulates the balance between cell survival and apoptosis through a cascade that primarily alters the function of transcription factors that regulate pro- and antiapoptotic genes. Dephosphorylation of 'Ser-473' of Akt triggers apoptosis and decreases cell proliferation. Also controls the phosphorylation of AKT3. Dephosphorylates STK4 on 'Thr-387' leading to STK4 activation and apoptosis (PubMed:20513427). Dephosphorylates RPS6KB1 and is involved in regulation of cap-dependent translation (PubMed:21986499). Inhibits cancer cell proliferation and may act as a tumor suppressor. Dephosphorylation of PRKCA and PRKCB leads to their destabilization and degradation. Dephosphorylates RAF1 inhibiting its kinase activity (PubMed:24530606). [UniProt]
仅用于科研。不用于诊断过程。未经明确授权不得转售。
生物信息学
蛋白别名: GTPase activating protein and VPS9 domains 1; PH domain leucine-rich repeat-containing protein phosphatase 2; PH domain leucine-rich repeat-containing protein phosphatase-like; PHLPP-like; protein phosphatase, Mg2+/Mn2+ dependent 3B; unnamed protein product
基因别名: AI481772; C130044A18Rik; KIAA0931; PHLPP2; PHLPPL; PPM3B; RGD1562857
UniProt ID: (Human) Q6ZVD8, (Mouse) Q8BXA7
Entrez Gene ID: (Human) 23035, (Mouse) 244650, (Rat) 498949